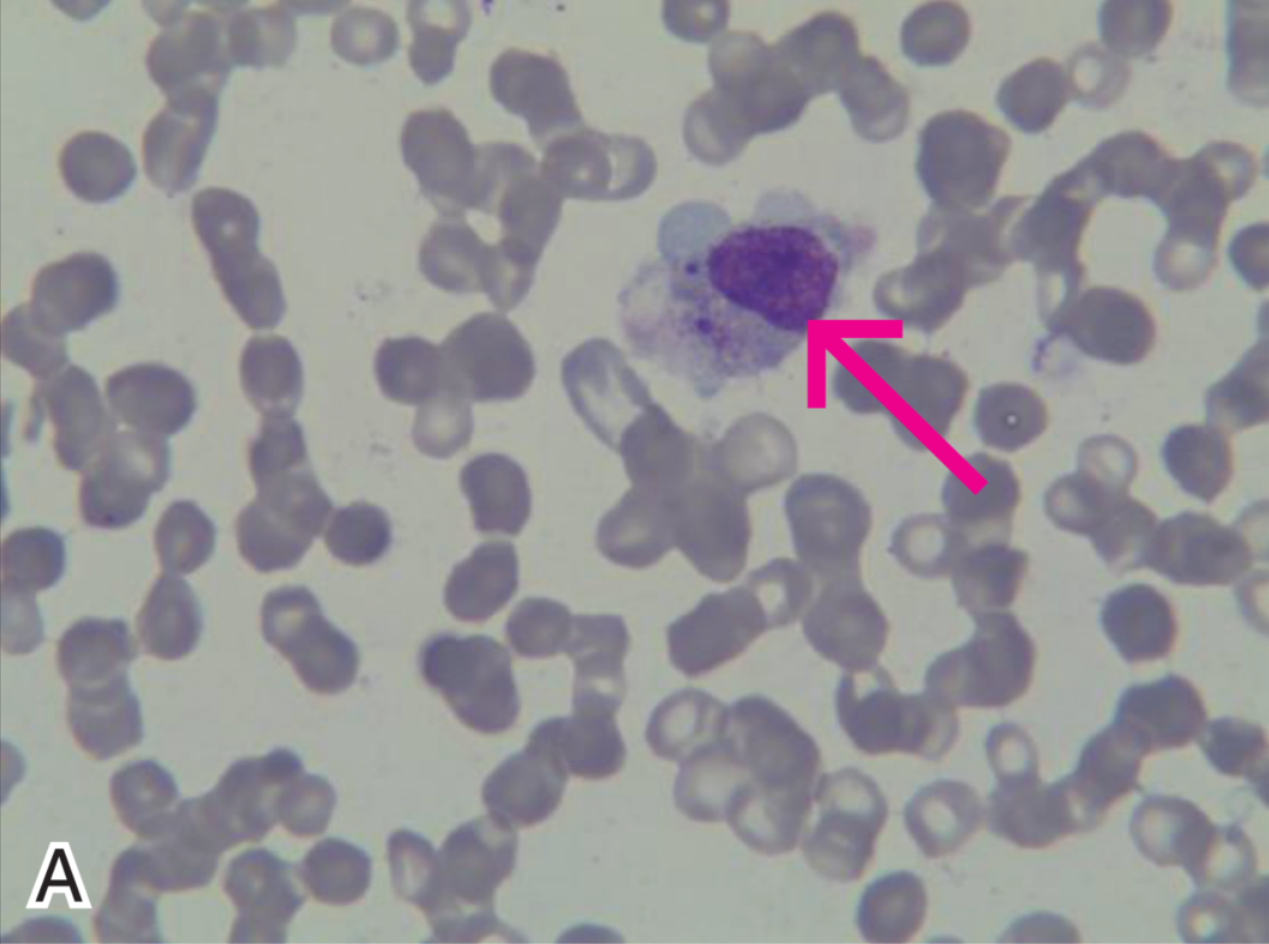

查看更多
密码过期或已经不安全,请修改密码
修改密码
壹生身份认证协议书
同意
拒绝
同意
拒绝
同意
不同意并跳过
东部战区总医院 国家肾脏疾病临床医学研究中心 全军肾脏病研究所 许书添 董建华 李世军 刘志红
病例介绍
主诉及现病史
患者女性,18岁,因“反复腹痛、腹胀27天,发热10天”于2017年2月10日入院。
1
2017年1月20日
患者出现脐周及左下腹闷痛不适,伴腹胀,逐渐停止肛门排便、排气,呕吐胃内容物,无发热。
2
1月23日
就诊于当地医院,胃镜示慢性浅表性胃炎伴胆汁反流、十二指肠球部炎症,腹部平片见肠管气粪影,未见气液平,对症治疗后腹痛、腹胀未缓解。
2
1月27日
查血白细胞(WBC)11.6×109/L、血红蛋白(HB)123g/L、血小板(PLT)332 ×109/L,血白蛋白(ALB)33.9g/L,肝肾功能正常,尿蛋白++、尿潜血+,腹部CT可见小肠壁水肿,对症治疗腹痛仍无明显缓解。
2
2月6日
患者出现发热,体温最高40.3℃,伴畏寒及寒战,无胸闷、胸痛,无心悸,抗干燥综合征抗原A(SSA)抗体及抗核抗体(ANA)阳性,补体正常,予抗感染及补液等治疗后,患者仍反复高热。
2
2月9日
来我院急诊,查血WBC 2.3×109/L、Hb 101g/L、PLT 105×109/L,单 核 细 胞2.6%,C 反 应 蛋 白(CRP)20.6mg/L,血白蛋白 26.6g/L,丙 氨 酸 氨 基 转 移 酶 (ALT)444 U/L,天冬氨酸氨基转移酶(AST)713U/L,乳酸脱氢酶4271U/L,甘油三酯(TG)1.7mmol/L,前白 蛋 白(PAB)411mg/L,血肌酐、胰酶正常。
3
2月10日
收入消化内科。发病以来,患者禁食,睡眠欠佳,大便如上述,小便正常,体重减轻2.5公斤。
患者既往口腔溃疡病史半年,个人史、月经婚育史以及家族史无特殊。
CULTURE
消化科住院期间
(2017年2月10日-2月16日)
体格检查
体温36.9℃,脉搏89次/分,呼吸18次/分,血压93/67mmHg,神志清楚,精神可,巩膜无黄染,全身淋巴结未扪及肿大,心肺查体阴性,腹膨隆,腹软,脐周压痛,肠鸣音正常(5次/分),移动性浊音阴性,双下肢无浮肿。
实验室检查
WBC 0.6×109/L,HB 97g/L,PLT 76×109/L,白介素-6(IL-6)60.25ng/L ,CRP 38.7mg/L,降钙素原(PCT)9.43μg/L,凝血酶原时间(PT)15.1s,活化部分凝血酶原时间(APTT)43.8s ,D-二聚体>40mg/L,纤维蛋白(原)降解产物945μg/ml,纤维蛋白原(FIB)2.77g/L,TG 2.28mmol/L;尿蛋白+、尿红细胞及白细胞阴性;ANA 1:320,抗双链DNA抗体阴性,抗SSA抗体、抗 Ro-52 抗体、抗小肠杯状细胞抗体(A-GAB)均阳性,补体 C3 0.603g/L;铁蛋白>1500μg/L;异型淋巴细胞 6%;骨髓细胞学示吞噬细胞占1%,组织细胞占 5.5%(图 1);甲型和乙型流感病毒抗原、出血热特异性抗体、结核感染T细胞检测、血培养均阴性。

图1 骨髓细胞学检查
A吞噬细胞占1%,组织细胞占5.5%;吞噬细胞内可见成熟红细胞、幼红、血小板、分叶核粒细胞(如箭头所示);
B 异常淋巴细胞占 2.5%(如箭头所示)
辅助检查
颅脑、胸部及腹部CT均未见明显异常。
治疗过程
入院后予奥硝唑、亚胺培南抗感染及退热、抑酸、营养支持等治疗,患者可自行排便排气,但仍有发热,体温波动在37℃~41℃,血三系进行性下降。2月12日下午高热41℃时突发意识不清、呼之不应、全身肌肉强直、牙关紧闭、眼球上翻,无大小便失禁,予气管插管接呼吸机辅助呼吸,苯巴比妥镇静,甲泼尼龙160mg及丙种球蛋白(20 g/d)静脉滴注。2月13日停用奥硝唑及亚胺培南,予万古霉素、伏立康唑、阿昔洛韦抗感染治疗,2月14日经全院病例讨论后诊断为“系统性红斑狼疮(SLE)、 噬血细胞性淋巴组织细胞增多症(HLH)”,予甲泼尼龙(500mg,疗程 3 天)、丙种球蛋白(20g,疗程5天)及美罗培南治疗后,体温逐渐降至正常(图2)。2月15日拔除气管插管。2月16日腹痛缓 解,血WBC升至4.6×109/L,PLT升至109×109/L,CRP下降,甲泼尼龙减量至250mg/d。2月16日转入肾脏科。

图2 药物治疗与体温、白细胞计数变化曲线图
CULTURE
肾脏科住院期间
(2017年2月16日-2017年3月14日)
体格检查
体温36.1℃,脉搏121次/分,呼吸30次/分,血压119/69mmHg;神清,精神差,全身皮肤满布透明水泡;双侧球结膜出血;口唇皲裂;双肺和心脏听诊未见异常;腹软,脐周压痛,肠鸣音正常;双下肢无水肿。
尿液
尿蛋白定量1.33g/24h(尿量为4700ml/24h),尿红细胞和尿糖阴性。尿N-乙酰-β-D-葡萄糖苷酶(NAG)62.4U/g·cr、视黄醇结合蛋白(RBP)8.6mg/L、尿中性粒细胞明胶酶相关载脂蛋白(NGAL)3259.1ng/ml。
血液
WBC 4.5×109/L,单核细胞 23.2%,中性分叶核粒细胞(N)67.7%,淋巴细胞(L)8.7%,PLT 109×109/L,Hb 102g/L,网织红细胞(Ret)1.62%;ALB 32g/L、球蛋白(GlO 41g/L,ALT 238U/L,AST 81U/L,血尿素氮(BUN)9md/dl,血肌酐(Scr)0.33md/dl,尿酸(UA)52mol/μl,乳酸脱氢酶(LDH)1173U/L,钙2.04mmol/L,磷0.5mmol/L,余电解质基本正常,利钠肽前体(pro-BNP)399.9pmol/L、CRP 1.1mg/L、PCT 0.459μg/L,D- 二聚体2.49mg/L,FIB1.17g/L。血异型淋巴细胞比例2%;铁蛋白>1500.0μg/L,可溶性白介素2受体1507U/ml;NK细胞活性14.17%(正常值>15.11%)。
免疫学
ANA 1:320,补体C3 0.6g/L,补体C4 0.13g/L;抗Ro-52抗体+++,SSA+++;狼疮抗凝因子、抗心磷脂抗体、抗β2-糖蛋白1抗体和抗中性粒细胞胞浆抗体阴性;免疫球蛋白(Ig)G 27.7g/L,IgA2.02g/L,IgE 52.1IU/ml,IgM 0.823g/L。淋巴细胞免疫分型:CD19+ 159/μl,CD3+ 701/μl,CD4+ 357/μl,CD8+ 322/μl。
其他自身免疫疾病相关抗体
抗丙酮酸脱氢酶复合物E2 亚单位三联体抗体弱阳性、抗线粒体抗体2型弱阳性。甲状腺功能正常,抗甲状腺球蛋白抗体、甲状腺过氧化物酶抗体、促甲状腺激素受体抗体均阳性。
病原体检查
结核感染T细胞检测阴性;EB病毒壳抗原(VCA)IgG 抗体+++,VCA-IgA 抗体阴性,VCA-IgM抗体阴性,抗EB病毒早期抗原(EA)IgG 抗体+,抗EB病毒核抗原(EBNA)IgG抗体+;EB病毒DNA(EBV-DNA)4.44×103copies/ml。巨细胞病毒(CMV)阴性。
辅助检查
双肾B超示左肾118mm×53mm×59mm,右肾121mm×49mm×60mm,双 肾 肾 盂 肾 盏扩张,输尿管上段扩张,左右侧宽均为5mm。心脏超声未见明显异常。头颅和腰椎磁共 振成像平扫未见异常。
诊断
① HLH:SLE合并巨噬细胞活化综合征(MAS),累及胃肠道、肝脏、血液、肾脏、输尿管和中枢神经系统,疾病活动指数17分;狼疮性肾炎;假性肠梗阻。② EBV感染。
CULTURE
治疗及随访
2月16日转入肾脏科重症监护病房,予甲泼尼龙80mg/d,辅以抗感染、保肾、抑酸等治疗;体温持续正常,CRP降至正常,血象三系升高,皮肤水疱消退。3月14日出院,予泼尼松45mg/d+环孢素A 100mg/d治疗。3月29 日复查,予甲泼尼龙12mg qd+环孢素A 50 mg q12h,尿蛋白转阴,尿红细胞18.2/μl,血常规、肝肾功能正常,ANA 1:256,补体C3略低。4月12日复查,穿孔素蛋白在NK细胞的表达仍低于正常范围,EBV-DNA<500copies/ml,CD107a激发试验提示NK细胞脱颗粒功能正常,提示该患者无遗传性HLH的基因背景,因此不必完善HLH分子遗传学检查,同时也证明本例患者为获得性HLH,而非原发性HLH。
CULTURE
诊疗分析
本例患者临床特点有两点。① 青少年女性,病程短,起病急。② 临床表现为多系统受累,累及消化、血液、泌尿及中枢神经系统。消化系统起病,肠梗阻、肝酶升高,肝脾不大;血液系统损害,血象三系进行性减少。泌尿系统表现为少量蛋白尿、镜下血尿,肾盂积水和输尿管上段扩张;神经系统表现为癫痫发作;肾外表现为发热(弛张热)、口腔溃疡、充血性皮疹、球黏膜出血;同时伴有多种自身抗体阳性和补体低下。本例患者符合1997年美国风湿病学会关于SLE的诊断标准。除SLE诊断明确,该患者有几点特殊之处。① 异型淋巴细胞增多:外周血查异型淋巴细胞6%,骨髓细胞学提示异型淋巴细胞4%;② 单核细胞比例升高:最高23.2%,EBV抗体阳性及EBV-DNA阳性 ,提示EBV 感染再激活;③ 铁蛋白>1500μg/L;④ TG逐渐升至2.28mmol/L;⑤ FIB逐渐低至<1.5g/L;⑥ 骨髓可见吞噬细胞1%;⑦ 低钠血症。因此患者病因需要考虑以下几种可能。
HLH又称噬血细胞综合征(HPS)
根据2004年修订的HLH标准(见表1),该患者满足8条中6条 ,故HLH诊断成立。2009年美国血液病学者在HLH-2004诊断标准的基础上,做了适当的修改,根据此标准,该患者符合其中9条,完全符合HLH临床诊断。

诊断SLE合并MAS
该患者系SLE合并HLH,属于自身免疫性疾病,因此称为SLE合并MAS,其诊断标准(见表2),至少1条临床标准加上至少2条实验室标准即可确诊。该患者可诊断为SLE合并MAS。

神经精神性狼疮
该患者病程中有癫痫发作,当时体温高达41℃,期间使用亚胺培南抗感染治疗,因此应与高热惊厥和药物性癫痫鉴别。高热惊厥一般好发于有高热家族史的6岁以下儿童,该患系18岁女性,首次高热并未惊厥,因此不符合高热惊厥。自1984年首次报告亚胺培南诱发药物性癫痫后,国内外陆续有亚胺培南致药物性癫痫的病例报告。目前认为亚胺培南诱发癫痫的机制可能与激活兴奋性神经元,抑制γ氨基丁酸介导的抑制性神经传导通路有关。该患者在癫痫发作前行头颅CT检查未见明显颅内占位等器质性病变,且停用亚胺培南后,癫痫未再发作,因此不能完全除外药物性癫痫。但是,该患者为狼疮活动时癫痫发作,且大剂量激素冲击治疗有效,因此临床考虑SLE合并神经精神性狼疮。此外,由于患者符合SLE合并MAS,从一元论角度考虑,SLE 并发癫痫发作可归因于MAS诊断。
SLE并发假性肠梗阻
青年狼疮患者,以典型的肠梗阻起病,有肠道动力障碍的影像学表现,例如肠腔明显扩张、肠壁水肿等,但未见到“靶征”和肠系膜充血水肿表现出的“栅栏”征象,因此不考虑狼疮肠系膜血管炎。该患者无机械性肠梗阻表现,病程中腹痛、腹胀自行缓解,给予激素治疗后 未再次发作,双肾超声提示肾盂积水、输尿管扩张,这些临床表现均符合狼疮并发假性肠梗阻。
EBV感染
该患者入院后持续高热,血、尿、粪等病原体检查均为阴性,仅呼吸道病原体抗体检查结果提示VCA-IgG、EA-IgG以及 NA-IgG 均为阳性,异型淋巴细胞和单核细胞升高,提示 EBV 感染再激活状态。进一步送检EB病毒载量,结果示EB病毒高度水平复制 ,证明EBV感染。
CULTURE
讨论
概述
HLH是由多种潜在病变引起淋巴细胞和组织细胞非恶性增生,产生细胞因子风暴所致的一种临床综合征。根据发病原因不同,HLH可分为原发性HLH和获得性HLH。原发性HLH常见于2岁以内儿童 ,获得性HLH多见于成人,常继发于感染(EBV、CMV、细菌及结核分枝杆菌等)、恶性肿瘤、风湿性疾病和器官移植术后,其中风湿性疾病相关的HLH在获得性HLH中占有重要地位。
SLE合并MAS发病机制
SLE合并MAS的发病率为0.9%~4.6%,自身免疫性疾病相关的MAS病死率高达46%。
其病理机制可能包括:自身抗体介导噬血现象;免疫复合物沉积在骨髓造血细胞;未控制的 T细胞活化致细胞因子(例如IL-1、IL-6)过度分泌。自身抗体和(或)免疫复合物致骨髓造血细胞对巨噬细胞敏感性增强 ,导致无法控制的噬血现象。T细胞分泌的细胞因子除参与上述过程外,还增加巨噬细胞活性。SLE相关的MAS患者出现无法控制的噬血现象主要是由于自身反应性淋巴细胞或同时发生的感染导致体内狼疮相 关的巨噬细胞功能出现紊乱和恶化。
SLE合并MAS与EBV感染之间的关系
本例狼疮患者的特殊之处在于同时并发MAS和EBV感染。EBV感染性疾病主要包括传染性单核细胞增多症(IM)、慢性活动性EBV感染(CAEBV)以及EBV相关噬血淋巴组织细胞增生症(EBV-HLH)。该患者均不符合IM和CAEBV的诊断标准,但其既符合EBV感染,又同时符合HLH诊断标准,因此考虑诊断EBV-HLH。
EBV感染可诱发SLE活动或复发,但EBV感染和SLE均是获得性HLH的病因,究竟是EBV感染诱发HLH还是EBV感染诱发狼疮活动并发HLH,其先后关系及因果关系很难清楚阐明。既往研究报告SLE患者外周血常伴大量EBV感染细胞,证实其跟疾病发作有必然联系。因此,可以推测EBV感染是SLE重要的诱发因素,而后促发假性肠梗阻和HLH等。
SLE合并MAS治疗方案
目前SLE并发MAS的治疗主要参照HLH-2004方案。MAS主要为糖皮质激素单药或联合环孢素A治疗。本例患者的治疗难点是狼疮活动期须使用大剂量激素治疗,但使用大剂量激素可能会加重感染或使病情恶化。因此本例的治疗方案是在大剂量激素冲击治疗的同时,联合使用静脉丙种球蛋白(IVIG)冲击治疗。尽管在病毒相关HLH的治疗策略中,IVIG的治疗价值仍不清楚,但一般认为IVIG有抗炎效应。此外,中枢神经系统受累的SLE患者合并感染时,可将IVIG作为一线用药。尽管 IVIG 没有直接抗病毒效应,但是其潜在的抗炎效应可以在细胞水平上抑制巨噬细胞活化、降低细胞因子活性和减轻细胞因子风暴。环孢素A对于治疗病情严重和激素抵抗的患者疗效显著。环孢素 A 是一种强效免疫抑制剂,对 T细胞有明显的抑制作用,糖皮质激素联合环孢素A可控制高细胞因子血症,在治疗风湿性疾病相关 HLH 中有显著疗效,早期使用可降低病死率。如果患者对以上治疗反应较差时,则推荐使用HLH-2004方案。本例患者采用小剂量激素联合环孢素治疗,有利于控制原发病和治疗HLH。
CULTURE
小结
本文报告1例以假性肠梗阻起病的SLE,随后并发HLH和EBV感染的患者。尽管HLH的确切病因并不知晓,但EBV感染再激活后同时出现狼疮活动期和HLH实属罕见。SLE持续高热不缓解且血象三系进行性下降,在完善骨髓细胞学检查和排查各种感染的同时,如果铁蛋白升高,临床医生须考虑HLH,立即给予大剂量激素冲击治疗原发病,如果感染持续存在或不能排除,可联合丙种球蛋白治疗。总之,早期积极有效控制细胞因子风暴和原发病是治疗SLE合并MAS的关键。
CULTURE

来源:《中国医学论坛报》2021年6月3日A5-A6版
查看更多